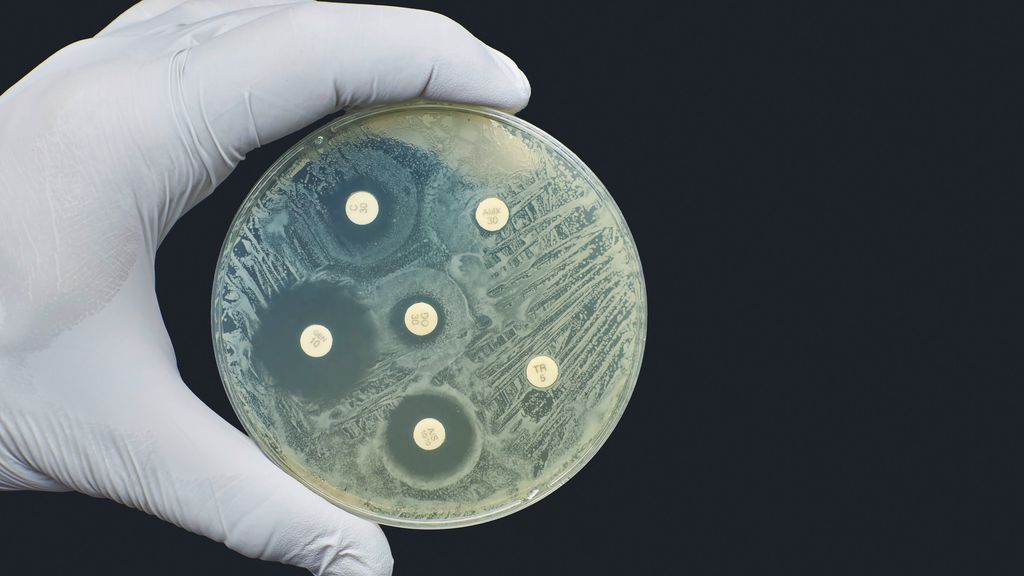

Bakterizid oder bakteriostatisch? Der Schmäh von gestern…
Bericht:
Reno Barth
Sie sind bereits registriert?
Loggen Sie sich mit Ihrem Universimed-Benutzerkonto ein:
Sie sind noch nicht registriert?
Registrieren Sie sich jetzt kostenlos auf universimed.com und erhalten Sie Zugang zu allen Artikeln, bewerten Sie Inhalte und speichern Sie interessante Beiträge in Ihrem persönlichen Bereich
zum späteren Lesen. Ihre Registrierung ist für alle Unversimed-Portale gültig. (inkl. allgemeineplus.at & med-Diplom.at)
Antibiotika werden üblicherweise als bakterizid oder bakteriostatisch eingestuft, wobei bakteriziden Substanzen bessere klinische Wirksamkeit zugeschrieben wird. Diese Hierarchie stammt, wie viele Paradigmen in der Antibiotikatherapie, aus der Zeit vor der evidenzbasierten Medizin. Die aktuelle Studienlage unterstützt die gewohnte Einstufung jedenfalls nicht. Optimale Dosierung, Pharmakokinetik, Gewebepenetration etc. sind relevantere Faktoren für die klinische Wirksamkeit eines Antibiotikums.
Evidenzbasierte Medizin ist ein relativ junges Konzept, während „Therapieprinzipien in der Medizin jahrhundertelang auf keinen oder sehr limitierten Daten basierten und daher oft mehr schadeten, als sie nutzten“, so Dr. Béatrice Grabein, leitende Ärztin der Stabsstelle Klinische Mikrobiologie und Krankenhaushygiene am LMU Klinikum München. Insbesondere die Infektionsmedizin sei durch Dogmen gekennzeichnet. Diese basieren aufunkontrollierten Fallserien, die über 70 Jahre alt sind, und wurden durch „Eminenzen“ gefestigt. Das betrifft nicht zuletzt die Antibiotika, deren klinische Verfügbarkeit randomisierten kontrollierten Studien (RTC) zu Sicherheit und Wirksamkeit deutlich vorausging. Grabein betonte in diesem Zusammenhang die eindrucksvolle Wirkung dieser Medikamente in Dosierungen, die anfangs so niedrig waren, „wie man sich das heute gar nicht mehr vorstellen kann“.
Antibiotika (Prontosil, Penicillin) zählten zu den ersten wirksamen Substanzen in der Medizin. Sie retteten Leben in Situationen, in denen zuvor keine Behandlungsoptionen mehr bestanden. Grabein: „Zum Zeitpunkt der Einführung von RCT als Mittel zur Einführung von Therapiestandards waren viele Paradigmen bereits etabliert – und wurden vielfach nicht mehr geändert.“ Das betraf nicht zuletzt die Antibiotika, deren Effekte von den Behandlern damals als „fast magisch“ wahrgenommen wurden.
Artifizielle Einteilung in bakterizid und bakteriostatisch
Die Medikamentenklasse der Antibiotika wird (unter anderem) eingeteilt in bakterizid (Bakterien werden durch das Antibiotikum abgetötet) und bakteriostatisch (das bakterielle Wachstum wird durch das Antibiotikum gehemmt). Bakteriostatische Antibiotika erfordern die Unterstützung durch die Abwehrsysteme des Wirts, um den infizierenden Erreger aus dem Gewebe zu eliminieren. Dies klingt klar und einfach, so Grabein. Allerdings sind die Details nicht unproblematisch, zumal diesen Kategorien eine relativ artifizielle mikrobiologische Definition zugrunde liegt, die an mehreren Stellen auf willkürlich gewählten Eckdaten beruht.
Diese orientiert sich an der MBC („minimum bactericidal concentration“) und der MIC („minimum inhibitory concentration“). Die MBC (deutsch: minimale bakterizide Konzentration, kurz MBK) ist definiert als diejenige Konzentration, bei der innerhalb von 18 bis 24 Stunden 99,9% der Erreger abgetötet werden. Die MIC (deutsch: minimale Hemmkonzentration, kurz MHK) ist die kleinste Wirkstoffkonzentration einer antimikrobiellen Substanz, die die Erregervermehrung in der Kultur noch verhindert. Als bakterizid wird ein Antibiotikum per definitionem bezeichnet, wenn sein MBC:MIC-Verhältnis kleiner als vier ist. Bei einem MBC:MIC-Verhältnis größer als vier spricht man von einem bakteriostatischen Antibiotikum.1
Diese Definitionen werfen allerdings Fragen auf, so die Expertin. Warum entschied man sich für eine 1000-fache Reduktion der Bakteriendichte? Warum über 18–24 Stunden? Zudem wurde mit einem ebenfalls willkürlich festgelegten Inokulum von >5x105KBE/ml eine fixe Bakterienkonzentration gewählt. Der Test wird in vitro in einem wässrigen Medium durchgeführt, hat also wenig mit der Situation in vivo zu tun. Die In-vitro-Daten sind nicht durch In-vivo-Studien validiert. Grabein: „Auch bakteriostatische Antibiotika töten Bakterien ab, und sie können das in vitro genauso schnell wie bakterizide Antibiotika, sie benötigen nur höhere Konzentrationen.“
Allerdings impliziert diese Nomenklatur, dass bakterizide Antibiotika im klinischen Einsatz den bakteriostatischen überlegen wären. Diese Annahme müsse allerdings infrage gestellt werden, wie Grabein ausführte, denn sie wurde anhand kleiner Fallserien von Patienten mit Endokarditis und teilweise mit Meningitis in den 1950er-Jahren aufgestellt. Diese zeigten, dass Therapien mit den als bakteriostatische Antibiotika eingestuften Tetrazyklinen und Makroliden häufiger in klinischem Versagen resultierten. Dazu sei allerdings festzuhalten, so Grabein, dass Tetrazykline und Makrolide aus zahlreichen Gründen nicht ideal für die Behandlung einer Endokarditis sind und in dieser Indikation heute auch nicht mehr eingesetzt würden. Mitte des 20. Jahrhunderts führten diese Arbeiten jedoch zur Annahme, dass bakteriostatische Antibiotika bakteriziden Antibiotika bei der Endokarditis unterlegen seien. Ebenso zeigten nichtrandomisierte Beobachtungsstudien bei Pneumokokkenmeningitis in der 1950er-Jahren eine niedrigere Letalität bei Penicillin-Monotherapie als bei der Kombination aus Penicillin und Tetrazyklinen. Daraus zog man den Schluss, dass bakterizide und bakteriostatische Antibiotika nicht miteinander kombiniert werden dürfen.
Kein Nachteil durch Einsatz bakteriostatischer Antibiotika
Daten aus qualitativ höherwertigen Arbeiten stützen diese Annahme jedoch nicht. Ein 2018 publizierter systematischer Review identifizierte insgesamt 56 seit 1985 publizierte randomisierte, kontrollierte Studien zu dieser Fragestellung.2 Erfasst wurden dabei unterschiedliche Indikationen wie komplizierte Haut- und Weichgewebeinfektionen, Pneumonien undkomplizierte intraabdominelle Infektionen. Teilweise waren die Studien auch Pathogen-fokussiert (z.B. Typhus, MRSA). In 49 der Arbeiten fand sich kein signifikanter Unterschied in der Wirksamkeit zwischen bakteriostatischen und bakteriziden Antibiotika. Das betraf, so Grabein, auch Bakteriämie, Pneumonie, Pest und Typhus, also Erkrankungen, bei denen man intuitiv denken könnte, sie müssten mit einem bakteriziden Medikament behandelt werden. In sechs Studien war das bakteriostatische Antibiotikum dem bakteriziden Antibiotikum sogar überlegen. Alle diese Studien wurden mit Linezolid durchgeführt. Nur in einer Studie war das bakterizide Antibiotikum überlegen. Verglichen wurde in dieser Arbeit Imipenem versus Tigecyclin bei beatmungsassoziierter Pneumonie (VAP). Allerdings unterstreicht Grabein, dass das bakteriostatische Tigecyclin in dieser Studie unterdosiert war.
Auch der in 22 Studien (21 retrospektive Beobachtungsstudien, 1 prospektive Kohorte) durchgeführte Vergleich von Daptomycin mit Linezolid bei Infektionen mit Vancomycin-resistenten Enterokokken spricht nicht für eine Überlegenheit des bakteriziden Daptomycins, wie ein systematischer Review mit Metaanalyse aus dem Jahr 2020 zeigt.3 Der Vergleich in dieser Indikation liegt nahe, da es bei Vancomycin-Resistenz nur eine sehr begrenzte Zahl von Optionen gibt. Die Auswertung zeigte keine Überlegenheit des bakteriziden Antibiotikums. Die Letalität war sogar (statistisch nicht signifikant) höher bei mit Daptomycin behandelten Patienten (OR:1,27; 95% CI: 0,99–1,63), wobei die Daptomycin-Dosis zwischen den Studien variierte (3,4–11,5mg/kg) und sich, so Grabein, generell im niedrigen Bereich bewegte.3
Für die Indikation Pneumonie fand ein Review mit Metaanalyse 43 randomisierte kontrollierte Studien mit mehr als 10000 Patienten, die jeweils zu ca. der Hälfte mit bakteriostatischen (Tigecyclin, Linezolid, Makrolide, Sulfonamide, Tetrazykline) und bakteriziden Antibiotika behandelt worden waren. Auch in diesem Fall ergab die Analyse keine signifikanten Unterschiede zwischen den Gruppen, weder im Hinblick auf den primären Endpunkt klinische Heilung noch auf einen der sekundären Endpunkte Sterblichkeit, mikrobiologische Eradikation, Therapieversagen oder Rezidive.4 Die Expertin: „Allein das Therapieprinzip bakterizid vs. bakteriostatisch macht also auch hier keinen Unterschied.“
Bakteriostatische Therapie kann auch bei Problemerregern wirksam sein
Bemerkenswerterweise trifft dies auch auf Infektionen mit als problematisch bekannten Mikroorganismen zu. Grabein wies in diesem Zusammenhang auf australische Erfahrungen in der Behandlung von MRSA-Infektionen mit Clindamycin, einem Lincosamid, hin. Grabein: „Lincosamide sind preisgünstig, penetrieren exzellent in Gewebe, erfordern kein therapeutisches Drug-Monitoring und hemmen die Produktion von Toxinen, die für viele der lebensbedrohlichen Manifestationen einer S.-aureus-Infektion verantwortlich sind. Die Aktivität der Lincosamide wird durch die Wachstumsphase oder die Größe des Inokulums nicht beeinflusst.“ In Australien werden sie selbst bei MRSA-Infektionen mit Bakteriämie eingesetzt. Und das mit gutem Erfolg, wie ein retrospektives Audit von 172 Patienten (2007–2020), die Antibiotika bei einer MRSA-Bakteriämie erhielten, zeigt. Die Infektionen waren zu 63% außerhalb des Krankenhauses erworben, in 57% der Fälle lag eine komplizierte Bakteriämie und in 11% eine Endokarditis vor. Endokarditispatienten wurden allerdings im weiteren Verlauf aus der Studie ausgeschlossen. Ausgangspunkt der Infektion war in 44% eine Haut- und Weichgewebeinfektion. Bei 157 Patienten enthielt das initiale Regime Vancomycin, 12 erhielten eine Clindamycin-Monotherapie, 62 Patienten wurde ein Clindamycin-dominiertes Regime (Clindamycin für >50% der intravenösen Therapie) verabreicht. Die Auswertung ergab sowohl in univariater als auch in multivariater Analyse unter Clindamycin-dominierten Regimen eine geringere Krankenhaussterblichkeit. In der Clindamycin-Gruppe traten auch keine Infektionen mit Clostridioides difficile auf.5 Grabein: „Alles in allem zeigen diese Daten, dass wir selbst bei einer MRSA-Bakteriämie nicht unbedingt ein bakterizides Antibiotikum brauchen.“
Damit stellt sich die Frage, ob die Testung von bakterizider Aktivität überhaupt hilfreich ist. Eine Antwort darauf liefert eine Studie mit 62 Endokarditispatienten mit S.-aureus-Infektion (13 MRSA, 49 MSSA), deren Erreger in vitro auf Toleranz gegenüber Oxacillin (oder Glykopeptiden) getestet wurde, wobei Toleranz definiert war als MBC:MIC-Ratio >32. Gefunden wurde Toleranz gegenüber Oxacillin zwar bei 63,2% der Stämme, diese verschlechterte das klinische Outcome jedoch nicht.6 Die Expertin: „In-vitro-Bakterizidie-Tests waren keine zuverlässigen Prädiktoren des klinischen Outcomes. Wenn ich also in vitro teste, ob ein Antibiotikum in einer bestimmten Situation bakterizid ist, hilft mir das klinisch nicht weiter.“
Bakterizide Antibiotika sind nicht immer bakterizid
Auch sei die Frage zu stellen, ob ein bakterizides Antibiotikum immer bakterizid ist und inwieweit dies vom Inokulum, also von der Erregerlast abhängt. Dies wurde in einem pharmakodynamischen In-vitro-Modell mit simulierten endokardialen Vegetationen unter simulierten humanen Dosierungsregimen für hohe (9,5log10KBE/g) und moderate Inokula (5,5log10KBE/g) von MSSA und MRSA untersucht. Ermittelt wurde die Aktivität von Nafcillin, Daptomycin, Vancomycin und Linezolid. Bei moderatem Inokulum zeigte sich bakterizide Aktivität nach vier Stunden für Nafcillin und Daptomycin und nach 32 Stunden für Vancomycin. Linezolid zeigte immer bakteriostatische Aktivität. Bei hohem Inokulum erreichten Nafcillin und Vancomycin während 72 Stunden keine bakterizide Aktivität, Daptomycin erreichte bakterizide Aktivität nach 24 Stunden. Grabein: „Ein hohes Inokulum hatte einen signifikanten Einfluss auf die Aktivität von Nafcillin und Vancomycin, einen minimalen Effekt auf Daptomycin und keinen Effekt auf Linezolid.“
Da bakteriostatische Antibiotika gleichsam auf die Mitarbeit des Immunsystems zur Elimination von Erregern angewiesen sind, stellt sich nicht zuletzt die Frage, ob bakterizide Antibiotika für neutropene Patienten benötigt werden. Antwort liefert ein systematischer Review klinischer Studien (drei prospektive, davon zwei RCT, zwei retrospektive) zu Linezolid für die Behandlung grampositiver Infektionen bei neutropenen Patienten (<1000 Granulozyten/mm3). Grabein: „Auch hier gab es keine Hinweise, dass das bakteriostatische Linezolid schlechter gewesen wäre als das bakterizide Vancomycin. In der einen randomisierten, kontrollierten Studie lag die Letalität unter Linezolid bei 5,6% im Vergleich zu 7,6% unter Vancomycin. Auch bei den klinischen Heilungsraten wurden keine Vorteile für das bakterizide Antibiotikum gefunden.“ Resistent gegenüber Linezolid war eines von 420 Isolaten.7
Ist bakterizid also besser als bakteriostatisch?
„Randomisierte, kontrollierte Studien unterstützen die behauptete Überlegenheit bakterizider Antibiotika nicht – auch nicht für schwer immunsupprimierte Patienten. Optimale Dosierung, Pharmakokinetik, Gewebepenetration etc. sind wichtiger für den klinischen Therapieerfolg“, fasste die Expertin zusammen. Die Biologie des bakteriellen Killings sei weit komplexer, als das simplizistische Konzept von bakteriostatisch versus bakterizid suggeriert. Nicht zuletzt ist die Forschung gefragt, denn bis heute gibt es keine RCT, die bakteriostatische versus bakterizide Antibiotika bei Meningitis oder bakterieller Endokarditis verglichen haben.8,9
Literatur:
1 Pankey GA, Sabath LD: Clin Infect Dis 2004; 38(6): 864-70 2 Wald-Dickler N et al.: Clin Infect Dis 2018; 66(9): 1470-4 3 Shi C et al.: J Glob Antimicrob Res 2020; 21: 235-45 4 Saleem N et al.: Clin Microbiol Infect 2022; 28(7): 936-45 5 Guthridge I et al.: Antimicrob Agents Chemother 2021; 65(9): e0034321 6 Pasticci MB et al.: Ann Clin Microbiol and Antimcrob 2011; 10: 26 7 Rafailidis PI et al.: Exp Rev Anti Infect Ther 2009; 7(4): 415-22 8 Nemeth J et al.: J Antimicrob Chemother 2015; 70: 382-95 9 Wald-Dickler N et al.: Clin Infect Dis 2018; 66(9): 1470-4
Das könnte Sie auch interessieren:
Ageismus und Wege dagegen – Frauen mit HIV in der ärztlichen Praxis
Seit 2021 ruft die WHO unter dem Hashtag #AWorld4AllAges zum Kampf gegen Ageismus weltweit auf und fordert mehr Forschung und Aufklärung zu diesem Thema.1 Gerade ältere Frauen*, die mit ...
Eradikation bei EHEC-Dauerausscheidung mit Antibiotika
Mit dem Akronym EHEC (enterohämorrhagische Escherichia coli) werden Shigatoxin (Stx) produzierende, humanpathogene E.-coli-Stämme (STEC) bezeichnet. Neben zytotoxischen, mit einem ...
Malaria: Diagnostik und Behandlung nach aktuellen Leitlinien
Gleich mehrere Leitlinien zum Thema Malaria wurden im vergangenen Jahr aktualisiert. Dies betrifft die WHO-Guidelines, die deutsche S1-Leitlinie und die Malaria Treatment Recommendations ...


